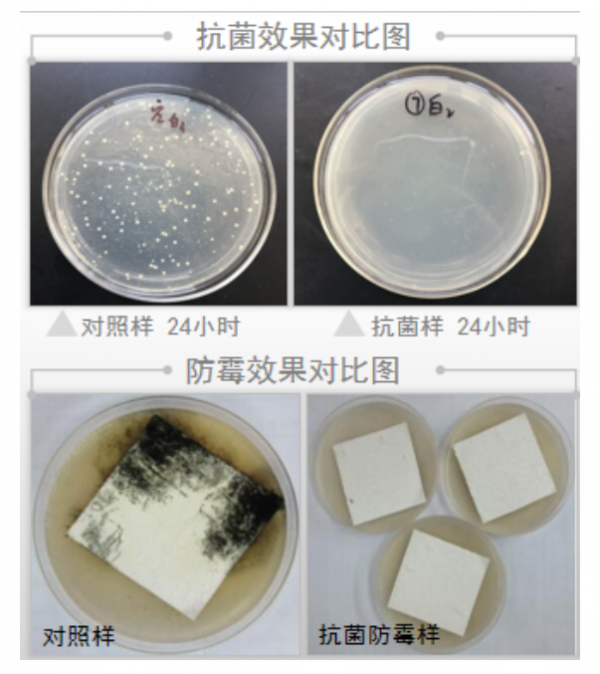
image.png

2021年4月13-16日,堪称行业风向标的第三十四届中国国际塑料橡胶工业展览会(CHINAPLAS 2021国际橡塑展)在深圳国际会展中心华丽启幕。本届展会集中了全球3,600多家国际展商,工业4.0、绿色及回收闭环科技、5G 橡塑支撑技术与医疗大健康成为展会四大主题。其中,抗菌塑料在展会中大显“神威”,成为橡塑行业绿色转型热捧的新“风口”。

晋大抗菌展位引关注
医疗大健康主展馆,以健康塑料为主,并云集保健及抗疫产品的橡塑生产技术供应商。晋大科技作为抗菌技术的代表应邀参展,前来咨询的国内外客商络绎不绝,引发重磅关注。

▲吴永鑫总经理带队,为来访客商提供咨询服务

▲晋大工作人员为国内外客商答疑解惑
抗菌塑料或能“一步到位”
2020年1月,国家发展改革委、生态环境部发布《关于进一步加强塑料污染治理的意见》,既针对多个行业提出禁止、限制一次性塑料用品管制要求,也提出推广应用替代产品、培育优化新业态新模式和增加绿色产品供给等措施,被称为史上“最严限塑令”。时隔一年后,这部新规已在全国范围正式实施,各地也纷纷推出地方版限塑措施,专项整治工作逐步推进,新旧塑料产业迎来升级挑战。

科技创新正成为规模型企业抢占行业风口的利器。在塑料行业整体绿色转型的当下,不少企业通过技术创新的方式应对挑战,同时不断提高产品质量,从而增强产品竞争力。比如新版限塑令实施以来,可降解塑料制品成为市场“新宠”,相关企业也在这一领域密集布局。然而目前对市面上一次性塑料制品存量的更新替换还需要时间,可降解替代只是第一步,可循环、可重复利用才是最终目的。因此抗菌塑料便成了另一种更为“超前”的替代方案。
抗菌塑料市场潜力巨大

▲抗菌塑料在日常生活中有着广泛的应用
抗菌塑料可通过抑制微生物的生长和繁殖,帮助塑料产品维持健康自洁,强化产品的耐用性同时延长其使用寿命,进而减少塑料废弃物的产生,在家电、建材、公卫、日用家居上都有着广泛的应用。据前瞻产业研究院发布的报告显示,2019年中国塑料制品产量高达8184万吨,约占全球塑料需求量1/4。与此同时,随着抗菌产品在下游应用领域渗透率的逐步提高,预计2021年国内抗菌材料市场规模达2,000亿元,其中家电、建材、日化领域抗菌材料都以塑料为主,抗菌塑料市场潜力巨大。

▲ 预计到2021年,国内 纺织抗 菌 材 料 市 场 规 模约为700亿,家电抗菌材料 市 场 规 模 约 为 380亿,日化抗菌材料市场规模约为380亿, 建卫抗 菌 材 料 市 场 规 模约为420亿,总规模 将达2000亿元。
抗菌塑料成“热门”
抗菌塑料不仅具备抗菌防霉功能,同时能延长产品使用寿命,绿色、安全、环保,成为了时下最为热门的新材料:
抗菌塑料制成厨卫、家居产品的表面或重要组件,避免因久放,细菌、真菌堆积在制品表面,而产生的油渍、黄变问题;有效抑制微生物的繁殖保持制品的清洁,阻断致病菌传染途径。
抗菌塑料不仅可以长效、安全抗菌,还有防霉功能。食品级抗菌塑料,防霉等级可达0级;可抑制细菌、霉菌等病原体的滋生繁殖,从而让厨卫、家居产品抗菌防霉,更健康。
解决了油渍、发霉、长斑等问题,不仅确保了塑料制品使用更健康,不再出现食安问题;更重要的是延长了厨卫、家居制品的寿命,耐用、实用,并具备绿色、环保功能。
▲ 抗菌塑料与普通塑料抗菌防霉效果实验对照
银系抗菌材料是主流
抗菌塑料解决了塑料霉变、黄变、老化及细菌堆积等根本性问题,很大程度上减少了冰箱综合症、空调病、洗衣机发臭等一系列“并发症”,有着广泛的市场应用。而抗菌塑料的制备又以银系抗菌材料为主,不仅拥有高效、广谱、长效的抗菌性能,同时又具备无毒、无异味、对环境无害的要求。

▲ 在所有的金属离子中银离子相对的抗菌能力最强,而且无毒无色,是当前抗菌材料发展的主流。

▲晋大科技明星产品磷酸锆载银抗菌检测报告,抗菌率>99.99%
此外,银抗菌材料能干扰核酸的合成,阻碍遗传信息的复制,包括DNA、RNA的合成,以及DNA模板转录mRNA等,从而杀灭病原菌和病毒等。

▲ 银离子能很好的破坏细菌和病毒蛋白结构,和蛋白中的硫原子结合,导致蛋白质丧失活性。新型冠状病毒恰好含有硫蛋白,硫蛋白位于病毒表面呈棒状结构。这也为银离子杀灭含硫蛋白的新型冠状病毒提供可能。
晋大牵头制定行业标准
晋大科技深耕抗菌十余载,是国内领先的抗菌功能材料及解决方案提供商。晋大抗菌产品以银离子抗菌剂为主要代表,其抗菌材料纯度高、粒径小、安全、无毒、绿色,拥有四十余项国家发明专利,多项技术已达国际先进水平。

▲ 晋大科技抗菌材料通过毒理性、皮肤刺激性检验
作为行业领先的抗菌材料供应商,晋大科技是纳米银、塑料等多项行业标准主要起草单位。今年3月,晋大纳米科技(厦门)有限公司携手中国塑料家居用品专委会召开【抗菌日用塑料制品】团体标准制定工作会议,年底【抗菌日用塑料制品】有望迎来团体标准,这也将使抗菌系列产品有法可依,抗菌日用塑料制品市场进一步规范,消费者利益得到保护,相关产业也能获得更好发展。

▲ 晋大科技是全国卫生产业管理协会抗菌产业分会(CIAA)副理事长单位及日本抗菌协会(SIAA)会员单位
目前,茶花、禧天龙、瑞康等日用塑料生产企业已率先研发使用抗菌产品,并加入了本次团标制定工作。有意向实现抗菌升级的相关企业可以联系我们,专业的技术工程师将为您提供个性化定制解决方案。









精彩评论